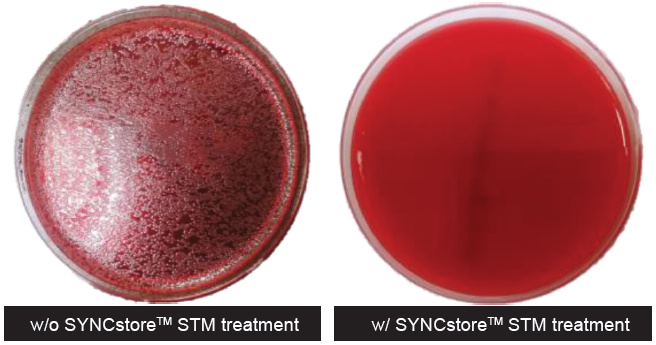
*

SYNCstore™ STM (SS1000)
Covid-19 Solutions/Sample Storage BufferThe SYNCstore™ STM is a specimen transport medium and designed for sample collection, shipping, and storage, especially suitable for nasopharyngeal/ oropharyngeal swabs. In addition, the SYNCstore™ STM can be used for virus/bacteria inactivation and DNA/RNA stabilization. Samples in SYNCstore™ STM stored at 22-27℃ is stable for 1 week and at -20℃ or -70℃ is stable for months to 1 year. The SYNCstore™ STM is compatible with most of nucleic acid extraction kits, including column based and magnetic beads based kits. The purified DNA/RNA from SYNCstore™ STM is suitable for subsequent nucleic acid tests (NAT) such as qPCR and qRT-PCR.